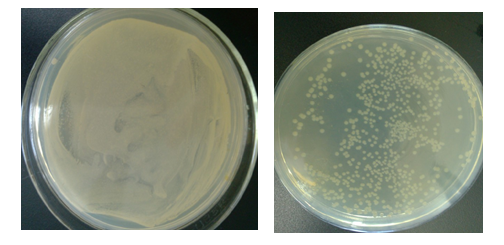
抗菌实验不同操作方法及细节对试验结果的影响

有时这种单菌落并非都由单个细胞繁殖而来的
276x280 - 13KB - JPEG
现有两个纯合的小麦品种:抗病低产和感病高产品种.已知抗锈病为显性.高产为显性.两对基因独立遗传.小麦锈病由诱菌感染引起.一个植株上所结的全部种子种植在一起.长成的植株称为一个株系.回答下列问题:(1)
386x221 - 50KB - PNG
8.铬是植物生长的微量元素.但土壤中过量的铬将抑制作物的生长.为探究铬离子对植物生长的影响.研究人员利用大蒜.不同浓度的重铬酸钾进行了如下实验:①大蒜生根:在适宜条件下培养大蒜.待根长至1-2cm时.
553x361 - 67KB - PNG

大肠杆菌感受态细胞制备及外源DNA的转化(图)-+生命经纬知识库
473x463 - 132KB - GIF

万深检测:HiCC-Z全自动菌落计数、抑菌圈测量、β-内酰胺酶检验仪|全自动菌落计数仪|抑菌圈测量仪|抑菌圈测定仪|β-内酰胺酶检验仪|抗生素效价测定仪|,乳酸链球菌素效价分析
700x400 - 96KB - JPEG
如图表示干细胞的三个发育途径.据图回答下列问题:(1)由A细胞形成的B细胞仍然保持着其特有的分裂能力.A细胞到C细胞的过程是由基因控制的.(2)若D细胞是胰腺细胞.则结构⑦所起的作用是对来自内质网的蛋白质进行加工.分类.包装和转运.(3)A细胞分化成D细胞的根本原因是基因的选择性表达.(4)若D细胞是正在衰老的细胞.该细胞 题目和参考答案
440x289 - 61KB - PNG
抗菌实验不同操作方法及细节对试验结果的影响
504x245 - 150KB - PNG

稀释涂布平板法问题
390x267 - 22KB - JPEG

稀释后用平板分离细菌单菌落_食品微生物检验
457x268 - 24KB - JPEG

划线和涂布法_食品微生物检验二_食品检测技
522x586 - 44KB - JPEG

食品学院继续教育专题网
478x306 - 53KB - JPEG

:平板分离操作过程
553x240 - 19KB - JPEG

】高中生物选修1课件:专题二 课题2《土壤中分
1080x810 - 79KB - JPEG

稀释涂布平板法_不确定_生物_高二_简单学习
640x480 - 186KB - JPEG

稀释涂布平板法_不确定_生物_高二_简单学习
640x480 - 208KB - JPEG
简介:而且采用稀释倒平台法也会使一些严格好氧菌因被固定在琼脂中间缺乏氧气而影响其生长,因此在微生物学研究
稀释涂布平板法是将菌液进行一系列的梯度稀释,然后将不同稀释度的菌液分别涂布到琼脂固体培养基表面,进行培养。在稀释度足够高的菌液里,聚集在一起的微生物将被分散成
稀释操作:1、将分别盛有9ml水的6支试管灭菌,并按10^1到10^6的顺序进行编号。2、用移液试管吸取1ml培养的菌夜,注入10^1倍稀释的试管中。用手指轻压移夜管上的橡皮,吹吸三次,使菌液与水充分混匀。3、从10^1倍稀释的试管中吸取1ml稀释液,注入10^2倍稀释的试管中,重复第二步的混匀操作。以此类推,直到完成最后一支试管的稀释。注意:移夜管需要经过灭菌。操作时,试管口和移夜管应在离火焰1~2cm处 涂布操作:1、将涂布器浸在盛有酒精的烧杯中。2、取少量菌夜(不超过0.1ml)滴加到培养基表面。3、将沾有少量酒精的涂布器在火焰上引燃,待酒精燃尽后,冷却8~10s。4、用涂布器将菌液均匀地涂布在培养基表面,涂布时可转动培养皿,使菌液分布均匀。 注意:1.将涂布器末端浸在盛有体积分数为百分之七十的酒精的烧杯中。取出时,要让多余的酒精在烧杯中滴尽,然后将沾有少量酒精的涂布器在火焰上引燃。
土壤稀释涂布平板法 cathyandhuhubo|2015-06-11 |举报 共享文档 共享文档是百度文库用户免费上传的可与其他用户免费共享的文档,具体共享方式由上传人自由设定。了解文
因为一般细菌浓度比较高,但是我们又很难把控这个浓度,所以就每个梯度都稀释出来,然后去涂板子,这样就可以保证有一个板子上的细菌长的菌落数目比较合适,同时再看下该浓度上下一个梯度是不是差不多是十倍关系,如果不是就说明你稀释的不够好,测量数据不够准确~
微生物接种方法-稀释涂布平板法是教育类高清视频,于2016-12-26上映,视频画面清晰,播放流畅,内容质量高。视频主要内容:通过写实的实验过程,对课堂中的知识点进行演示。覆盖整个高中阶段学科知识点,以权威精确的实验过程展现给。。
平板划线法与稀释涂布平板法的区别 暂无评价|0人阅读|0次下载|举报文档 阅读已结束,如果下载本文需要使用 0下载券下载 想免费下载本文? 立即加入VIP 你可能喜欢 您的评论
稀释涂布平板法是将菌液进行一系列的梯度稀释,然后将不同稀释度的菌液分别涂布到琼脂固体培养基表面,进行培养.在稀释度足够高的菌液里,聚集在一起的微生物将被分散成
平板划线法和稀释涂布平板法各有什么优缺点?可能的话说明各在什么时候使用。谢谢.可能的话说明各在什么时候使用。谢谢展开一、平板划线分离法由接种环以菌操作沾取